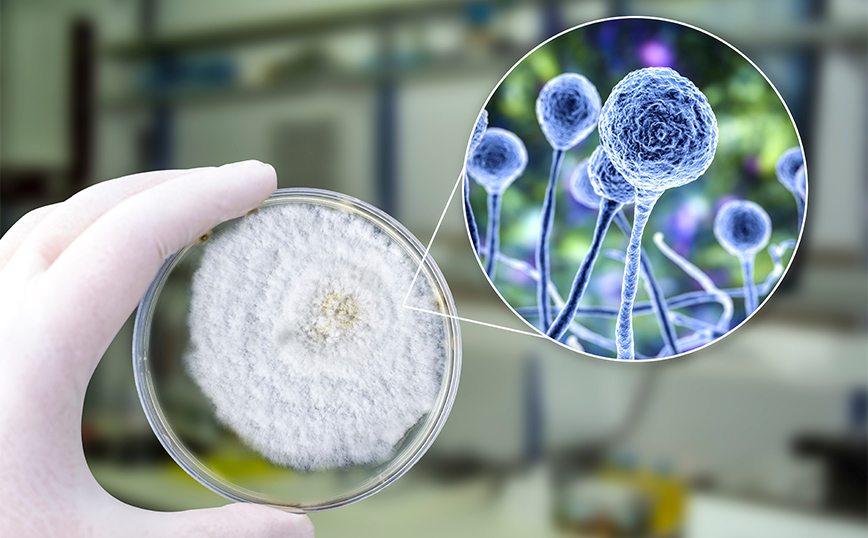

Συναγερμός έχει σημάνει στις ΗΠΑ από την εξάπλωση του μύκητα Candida auris, που σκοτώνει έως και το 60% των ανθρώπων που μολύνει. Η μεγάλη ανησυχία για την «εποχή των μυκήτων» έρχεται σε συνδυασμό με προειδοποιήσεις από τον Παγκόσμιο Οργανισμό Υγείας, αλλά και μια σημαντική έρευνα, που δείχνει πως η άνοδος της θερμοκρασίας, λόγω της κλιματικής αλλαγής, μπορεί να κάνει τους μύκητες πιο ανθεκτικούς και άρα πιο επικίνδυνους για τον άνθρωπο.
Ενώ τα βακτήρια και οι ιοι είναι ευρέως γνωστοί για την πρόκληση λοιμώξεων και ασθενειών, ακόμη και με τη μορφή πανδημίας, οι παθογόνοι μύκητες μέχρι σήμερα δεν είχαν τραβήξει την προσοχή, καθώς θεωρούνταν υπεύθυνοι για πολύ μικρότερα προβλήματα, ιδιαίτερα σε υγιείς ανθρώπους. Ο λόγος είναι πως η θερμοκρασία του ανθρώπινου σώματος είναι συνήθως αρκετά υψηλή, δημιουργώντας ένα μη φιλικό περιβάλλον για την επιβίωσή των περισσότερων μολυσματικών μυκήτων.
Ωστόσο, σύμφωνα με την έρευνα των επιστημόνων του Πανεπιστημίου Duke της Βόρειας Καρολίνα αυτό ενδεχομένως να αλλάξει. Οι επιστήμονες κρούουν το κώδωνα του κινδύνου για ένα δυστοπικό σενάριο που παραπέμπει στην δημοφιλή σειρά του HBQ «The Last Of Us», όπου ένας μύκητας προσαρμόζεται στην θερμοκρασία του ανθρώπινου σώματος και εξαπλώνεται με τη μορφή πανδημίας.
«Για αυτό ακριβώς μιλάμε – αφαιρώντας βέβαια το κομμάτι των ζόμπι που παρουσιάζονται στη σειρά», σημειώνει η Ασίγια Γκούσα, μια εκ των ερευνητών που υπογράφουν τη σχετική μελέτη. Μεταξύ των περίπου 300 μυκήτων, που είναι παθογόνοι για τον άνθρωποι, οι πιο γνωστοί είναι ο Candida auris, ο Aspergillus και ο Cryptococcus.
Επί του παρόντος οι μύκητες θεωρούνται πιο επικίνδυνοι για ανοσοκατασταλμένα άτομα, ο οργανισμός των οποίων δεν διαθέτει τις αναγκαίες άμυνες για να αποτρέψουν την εξάπλωσή τους.
Η άνοδος της θερμοκρασίας, παγκοσμίως, φαίνεται πως ανατρέπει τα δεδομένα, όπως διαπιστώνουν οι ερευνητές, σημειώνοντας πως από τη μια θα αυξηθούν οι ασθένειες από μύκητες, αλλά ταυτόχρονα αυτές οι μολύνσεις θα μπορούσαν να γίνουν πολύ πιο σοβαρές για τους ανθρώπους.
Στην έρευνα επισημαίνεται πως οι υψηλότερες θερμοκρασίες έχουν οδηγήσει σε γρήγορες γενετικές μεταλλάξεις παθογόνων μυκήτων. Αυτές οι μεταλλάξεις θα μπορούσαν να ενισχύσουν την προσαρμογή τους σε θερμότερα περιβάλλοντα, όπως το ανθρώπινο σώμα, αλλά και την αντοχή τους στα φάρμακα.
«Πρόκειται για μια συναρπαστική μελέτη, η οποία δείχνει πως η αύξηση της παγκόσμιας θερμοκρασίας μπορεί να επηρεάσει την εξέλιξη των μυκήτων σε απρόβλεπτες κατευθύνσεις. Πρόκειται για μια ακόμη πτυχή που θα πρέπει να μας ανησυχεί σχετικά με την υπερθέρμανση του πλανήτη», τονίζει ο Αρτούρο Κασαντίβαλ, πρόεδρος μοριακής μικροβιολογίας και ανοσολογίας στο Πανεπιστημίο Johns Hopkins.

Σε σχετικές έρευνες έχει παρατηρηθεί πως χρόνο με το χρόνο οι παθογόνοι μύκητες γίνονται όλο και ανθεκτικοί στα φάρμακα και προς το παρόν, υπογραμμίζουν οι επιστήμονες, δεν υπάρχουν εναλλακτικές λύσεις.
Τον Οκτώβριο του 2022, ο ΠΟΥ σε έκθεσή του υπογράμμιζε πως «παρά το γεγονός πως οι μύκητες αποτελούν αυξανόμενη απειλή για την ανθρώπινοι υγεία, η αντιμετώπιση των μυκητιάσεων λαμβάνει μικρή προσοχή και λίγους πόρους».
Στόχος του ΠΟΥ φαίνεται πως είναι να αυξήσει την παγκόσμια επιτήρηση των μυκήτων και να χρηματοδοτήσει περισσότερες έρευνες, ώστε να εξαχθούν συμπεράσματα και να υπάρξουν οι αναγκαίες προτάσεις για τη διασφάλιση της δημόσιας υγείας. «Υπάρχουν στοιχεία που υποδηλώνουν πως τόσο η συχνότητα εμφάνισης όσο και το γεωγραφικό εύρος των λοιμώξεων από μύκητες επεκτείνεται παγκοσμίως λόγω της κλιματικής αλλαγής», υπογραμμίζει η έκθεση.